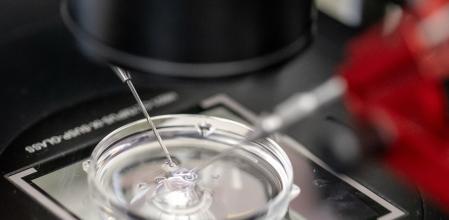
Los tratamientos en las clínicas de reproducción han aumentado en un 40% los últimos 5 años&nbsp;

Que no se les pase el arroz: Francia anima a los jóvenes a congelar óvulos y espermatozoides
Fomentar la natalidad
Enviará cartas a todos los ciudadanos de 29 años para recordarles que el reloj biológico no perdona
Los tratamientos en las clínicas de reproducción han aumentado en un 40% los últimos 5 años

Los impulsores de la medida repiten que no se trata de presionar a nadie, tampoco de obligar a los jóvenes a procrear –los sueldos que se pagan y el alquiler de los pisos no están para alegrías con hijos– ni de imponer una edad para ser madres o padres. Aquí lo que se pretende es concienciar a los jóvenes de que el reloj biológico para tener hijos no perdona. Ponerlos en alerta para que no se les pase ese arroz.
La medida la impulsa Francia. El próximo mes de junio todos los ciudadanos de 29 años de ese país recibirán una carta sobre fertilidad enviada por el Gobierno. El mensaje será claro. Las manecillas de ese reloj biológico van muy rápido y se recuerda que la tasa de fertilidad desciende justo antes de cumplir 30 años.
Y además esa edad de 29 tiene otra explicación: es el umbral a partir del cual las mujeres pueden congelar en Francia sus óvulos sin necesidad de justificación médica.
La tasa de fertilidad no para de descender y el error es pensar que la ciencia, cuando se quieren tener hijos, ya ayudará a procrear
Muchos de los jóvenes que recibirán esa misiva seguro que aún no se han planteado ser madres o padres –en España la media de las mujeres que tienen hijos está en los 32 años– así que lo que se pretende es que adelanten a los acontecimientos.
Se les anima a congelar óvulos y espermatozoides, cuando el índice de fertilidad es aún alto, para usarlos después cuando decidan tener hijos si esas criaturas no llegan de forma natural. Vamos, curarse en salud.

Manuel Izquierdo, director médico de IVF-Life, grupo internacional de clínicas de reproducción asistida, con sedes en Alicante, Madrid y Donostia, aplaude la iniciativa. “El simple hecho de que se empiece a debatir y a proponer públicamente medidas para afrontar el descenso de natalidad ya es positivo”.
Lo estima así “porque desde el punto de vista clínico, fomentar el conocimiento real sobre la fertilidad y el impacto de la edad en la reproducción es fundamental para que las personas puedan tomar decisiones que, en caso de que no se adopten a tiempo, pueden tener nefastas consecuencias”.
El perfil
Edad materna avanzada
Manuel Izquierdo dibuja el perfil de pacientes que llegan a sus clínicas. “Por un lado, están las personas que acuden por problemas reproductivos de origen médico o genético, que pueden afectar a pacientes de cualquier edad. En estos casos hablamos de alteraciones ováricas, factor masculino severo, enfermedades hereditarias o patologías que comprometen la fertilidad”. Pero hay otro grupo cada vez más numeroso en la actualidad. “Son parejas -continúa este médico- con dificultades para concebir asociadas principalmente a la edad materna avanzada, aunque el factor masculino también influye en muchos casos de infertilidad en la pareja. El retraso en la maternidad es un fenómeno claramente consolidado en España (la edad media para el primer hijo supera ya los 32 años), y clínicamente vemos cómo el factor edad se ha convertido en uno de los principales motivos de consulta.
Manuel Izquierdo revela que muchas personas llegan a su consulta “cuando la reserva ovárica ya está disminuida o cuando la calidad seminal se ha visto afectada, y desconocían que existían opciones como el estudio precoz de fertilidad o la preservación de gametos”. Así que, reitera, “iniciativas como la de Francia pueden facilitar que las decisiones reproductivas se tomen con mayor conocimiento y menos urgencia”.
Este médico, especializado en resolver casos complejos, pone el foco en el núcleo del problema: “Culturalmente, existe la percepción de que hay tiempo para tener hijos, así que no se contempla la posibilidad de infertilidad o el impacto de la edad hasta que se intenta concebir”.
Iniciativas como la de Francia pueden facilitar que las decisiones reproductivas se tomen con mayor conocimiento y menos urgencia”
En ese mundo no hay varitas mágicas: “La criopreservación de gametos es una herramienta muy útil para preservar opciones reproductivas –apunta Manuel Izquierdo– pero no es una solución mágica”.
La percepción extendida de que la tecnología puede resolver hoy cualquier limitación biológica es un mal aliado. “La reproducción asistida ofrece soluciones muy eficaces (cada día más), pero no elimina completamente el impacto del envejecimiento reproductivo”, recuerda este experto.
Pero algo sí está cambiando: “En nuestras clínicas, estos tratamientos han crecido un 40 % en los últimos cinco años, lo que refleja un vuelco social”.

El doctor Izquierdo pide que “las políticas públicas no traten este tema solo como un problema demográfico, sino como un asunto de salud pública, educación y apoyo social que impacta directamente en la vida de las personas”.
Considera que reducirlo a cifras de reemplazo generacional puede deshumanizar una cuestión que, en realidad, tiene un profundo impacto en la vida emocional”.
La tasa de fertilidad en España es una de las más bajas de Europa; 1,10 hijos por mujer, muy por debajo del nivel necesario de reemplazo generacional
España está entre los países con menos fertilidad en Europa y una de las tasas de fecundidad más bajas del continente. En 2024 la tasa de fertilidad fue aproximadamente 1,10 hijos por mujer, muy por debajo del nivel necesario de reemplazo generacional de 2,1 (el número promedio de hijos que cada mujer debe tener (o pareja) para que una población se mantenga estable.
La media de la UE ronda aproximadamente 1,38 hijos por mujer, y la mayoría de países europeos se sitúan por debajo de 1,6. Esto sitúa a España por debajo de la media europea y como uno de los países con la tasa más baja, especialmente cuando se compara con países como Francia (que tiene una tasa de 1,66 hijos)
